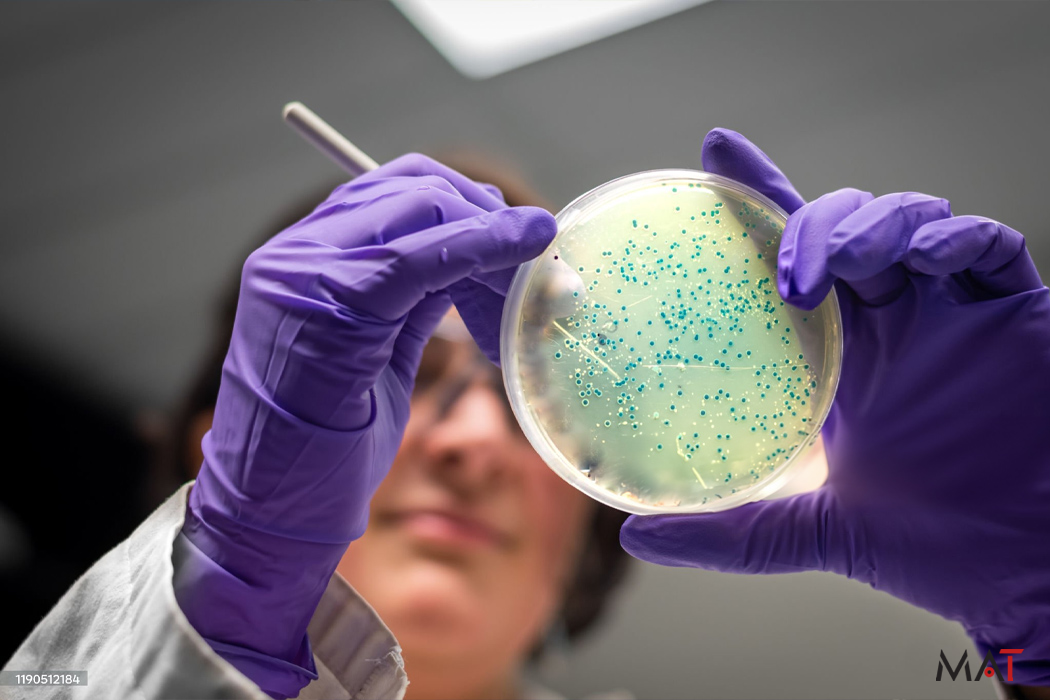
recall-011.png

In an unprecedented enforcement action, the U.S. Food and Drug Administration (FDA), alongside the Department of Justice and the U.S. Marshals Service, targeted the proliferation of potentially dangerous 7-hydroxymitragynine (7-OH) in dietary supplements and foods. With a successful operation in Missouri, authorities seized a staggering 73,000 units of these products, valued at approximately $1 million. This move underscores the FDA’s commitment to safeguarding public health and protecting American consumers from substances that can pose serious health risks.
The Seizure Details and Risks
The concentrated 7-OH, an opioid-like compound found added in certain liquid shots and tablets, has emerged as a major concern due to its ability to bind to opioid receptors, leading to potential abuse. Despite its rising use, the substance’s presence in dietary supplements is illegal, as it doesn’t meet the necessary safety standards and lacks FDA approval for medical use. Authorities targeted three firms in Missouri, signaling no tolerance for products undermining public safety.
Agency’s Coordinated Efforts
FDA Commissioner Marty Makary emphasized the importance of this bold action to safeguard communities and children from the lurking dangers of 7-OH. The FDA, supported by Missouri’s Department of Health and Senior Services, highlighted the seamless federal-state collaboration. Earlier this year, the FDA advised on scheduling 7-OH under the Controlled Substances Act and issued warnings to firms distributing such products illegally
– The action by the FDA reflects a proactive stance against new and emerging drug threats.
– The agency’s prior warnings highlight the ongoing monitoring for illegal product distribution.
– Missouri’s involvement demonstrates effective state and federal partnership.
– Targeting products accessible to youth shows a focus on vulnerable populations.
Aggressive enforcement against unlawful products containing 7-OH highlights the FDA’s rigorous commitment to public safety. Continued vigilance is essential as new unapproved substances emerge in the market, posing potential health risks. Consumers need to be informed and cautious about supplement ingredients. Overall, education and awareness remain vital in combating the unregulated distribution of hazardous substances. The seizure in Missouri sets a significant precedent, warning manufacturers of the consequences of non-compliance with established regulations. This strategic intervention not only protects consumers today but also reinforces a future where public health is prioritized through decisive regulatory enforcement.

This article has been prepared with the assistance of AI and reviewed by an editor. For more details, please refer to our Terms and Conditions. We do not accept any responsibility or liability for the accuracy, content, images, videos, licenses, completeness, legality, or reliability of the information contained in this article. If you have any complaints or copyright issues related to this article, kindly contact the author.